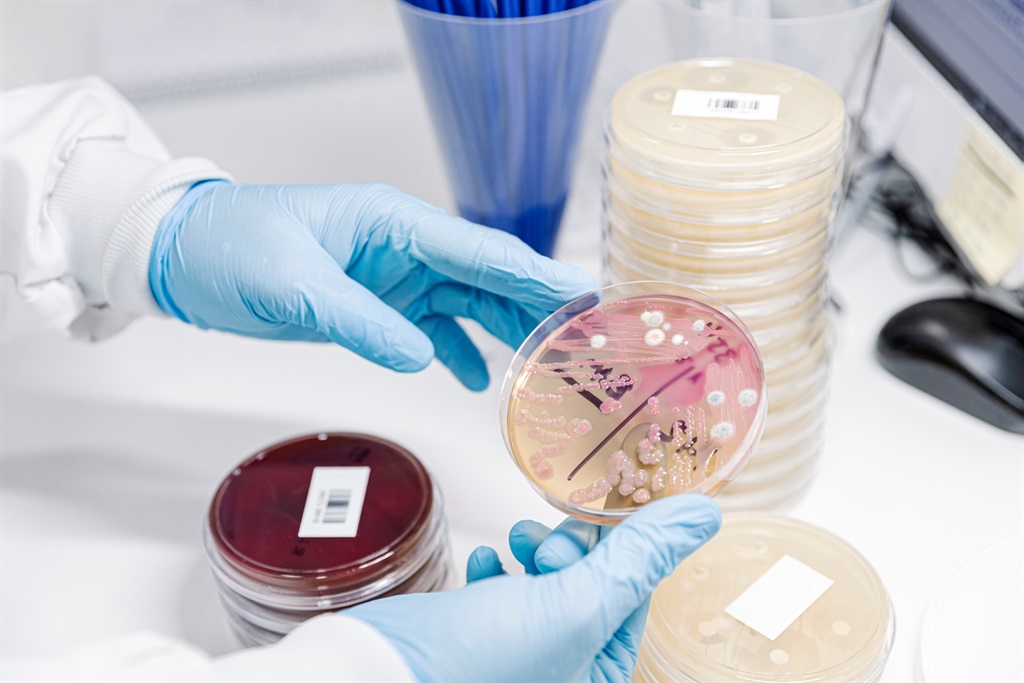
Fungal Testing Kits Industry

The global fungal testing equipment industry size is expected to increase significantly between 2023 and 2033, rising at a pace of 10.1% CAGR and reaching US$ 4504 million by 2033, with a predicted Fungus Testing Kits Market size of over US$ 1.72 billion as of 2023. As predicted by Future Market Insights, diagnostic laboratories will hold a sizable market share of more than 51.8% in 2023.
FMI conducted a comparative analysis of market growth rates and future opportunities in the global fungus testing equipment market. The fungal testing kits industry is regulated by device restrictions, illness epidemiology, and the rate of product acceptance, as well as the influence of macroeconomic and industrial factors.
Discover Our Expert Analysis with Our Sample Report! https://www.futuremarketinsights.com/reports/sample/rep-gb-12418
The development of low-cost kits, as well as increased attempts to raise awareness of fungal diseases, is a significant advancement in the fungal testing kits market.
Manufacturers of Fungal Diagnostic Kits Have Numerous Opportunities:
The development of PCR techniques has enabled scientists to find novel genes, gene expression, and genetic mutation in an organism’s tissues, which has controlled the comparative examination of illnesses and normal tissues, and this may raise demand for fungal testing kits.
Expanding healthcare research and development expenditures and the adoption of molecular diagnostic testing provide the profit potential for the growth of the fungal testing kits market.
Challenges Blocking Demand for Fungal Testing Kits:
Poor social awareness of infections, particularly in low and middle-income nations such as India, Africa, Columbia, Mexico, and China, has led to seeking medical help from office-based healthcare setups that profess to treat the disease naturally using traditional remedies.
These societal factors have a significant impact on the transmission of sexually transmitted illnesses and genital diseases. Among the many possible causes are lack of education, poverty, and social inequality. These factors inhibit the fungal testing kits market growth.
Regional Outlook:
The fungal testing kits market has positioned North America as the global powerhouse. As infectious diseases are so common, this is understandable. There is a greater demand for fungal testing kits due to the increased awareness of numerous fungal infections in this area.
The fungal testing kits industry is expanding in Asia-Pacific. With rising healthcare costs and a large patient base, these countries hold great growth potential. These previously mentioned countries are also rife with infections like candidiasis and invasive fungal illnesses. The fungus testing equipment market is growing as a result of this.
Our Analyst Is Here To Assist You With Any Questions Get In Touch Now! https://www.futuremarketinsights.com/ask-question/rep-gb-12418
Key Takeaways:
- The market’s molecular test segment forecasts a CAGR of 7.5% from 2023 to 2033 in the test type category.
- The fungal testing kits industry’s diagnostic laboratory sector is likely to experience a CAGR of 7.4% between 2023 and 2033.
- By 2033, the United States fungus testing equipment market to advance at a CAGR of 9.8% and reach US$ 1210.95 million.
- By 2033, the China fungal testing kits industry may have climbed at a CAGR of 12.9% and be worth US$ 488.22 million.
- By 2033, the Canadian market may have expanded by 8.4% CAGR to reach a value of US$105.55 million.
- By 2033, the German fungal testing kits industry can have risen rapidly to 12.6% and be valued at US$ 352.17 million.
- The market in the United Kingdom is to evolve at a CAGR of 9.8% and reach US$ 250.61 million by 2033.
Fungal Testing Kits Business Forecast for the Future:
Thermo Fisher Scientific, PerkinElmer Inc., ELITech Group, Merck KGaA, bioMerieux SA, GenMark Diagnostics Incorporation, C.P.M. Diagnostic Research, F.Hoffman LaRoche Limited., PCRmax, Bioquochem, Norgen Biotek, Biomed Diagnostics Incorporation, and Hologic Inc. are among the major fungal testing kits manufacturers.
To develop profitable diagnostic kits, companies are focused on partnerships, collaborations, and acquisitions.
Crucial Strategic Innovations:
Acquisition:
- ELITech Group acquired the medical goods business Gonotec GmbH on July 14, 2021.
- Thermo Fisher Scientific officially confirmed the acquisition of Brammer Bio in 2019. This acquisition aided Thermo Fisher Scientific in expanding its laboratory services and product line for fungus testing equipment.
Innovative Strategies Unveiled: Customization at the Core of Our Report! https://www.futuremarketinsights.com/customization-available/rep-gb-12418
Key Segments:
By Test Type:
- Molecular Test
- Chromogenic Test
- Others
By Sample Type:
- Skin
- Urine
- Vaginal secretions
- Blood
- Cerebral
- Others
By Application:
- Research
- Susceptibility Testing
- Medical Diagnosis
- Others
By End User:
- Diagnostic Laboratory
- Hospitals
- Pharmaceutical Companies
- Research and Academic Institutes
By Region:
- North America
- Latin America
- Europe
- South Asia
- East Asia
- Oceania
- Middle East and Africa (MEA)
About Future Market Insights (FMI)
Future Market Insights, Inc. (ESOMAR certified, recipient of the Stevie Award, and a member of the Greater New York Chamber of Commerce) offers profound insights into the driving factors that are boosting demand in the market. FMI stands as the leading global provider of market intelligence, advisory services, consulting, and events for the Packaging, Food and Beverage, Consumer Technology, Healthcare, Industrial, and Chemicals markets. With a vast team of over 5000 analysts worldwide, FMI provides global, regional, and local expertise on diverse domains and industry trends across more than 110 countries.
Contact Us:
Future Market Insights Inc.
Christiana Corporate, 200 Continental Drive,
Suite 401, Newark, Delaware – 19713, USA
T: +1-845-579-5705
For Sales Enquiries: sales@futuremarketinsights.com
Website: https://www.futuremarketinsights.com
LinkedIn| Twitter| Blogs | YouTube